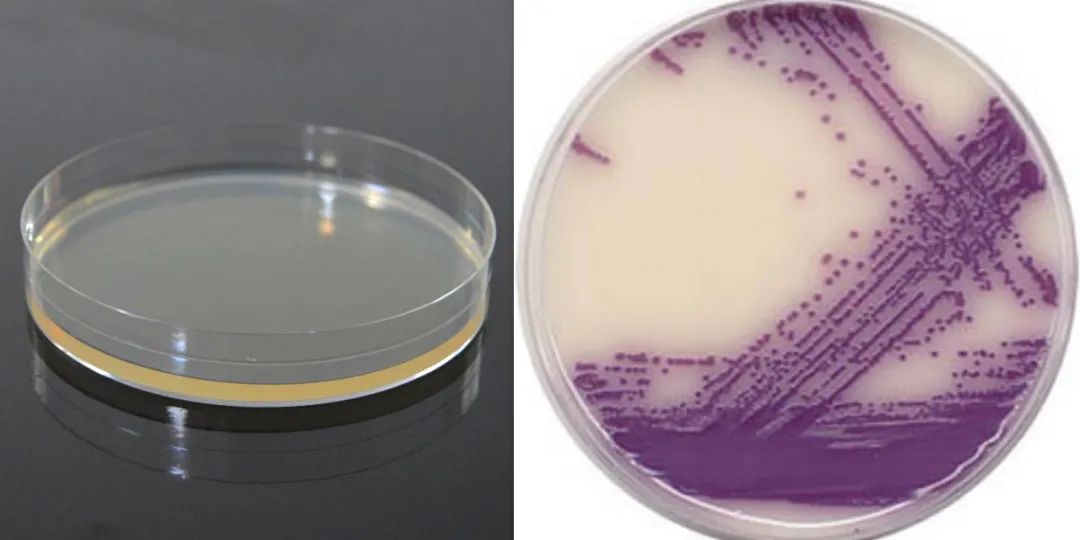
当微生物化身艺术品……

固体培养基

微生物检测中培养基的质量控制_进行讨论
图片尺寸2848x1728
无胆甾原体价格_无胆甾原体厂家_仪器信息网
图片尺寸496x333
lb显色培养基 - 自主开发产品 - 迈博生物科技有限公司
图片尺寸394x369
关于微生物实验室干粉培养基的管理及保存-帖子-标准物质网
图片尺寸1080x1071
草酸钾兔血浆培养基的配制 - 上海一研生物科技有限公司
图片尺寸1024x768
微生物在固体培养基上生长是否有延滞期? - 微生物 - 小木虫 - 学术
图片尺寸601x800
青岛拓普生物供应topbiol平板/一次性平板(90mm)na 0.25%青霉素酶-青
图片尺寸1314x986
固体培养基(其他人物相关)_技点百科
图片尺寸1280x1163
科研实验试剂 半固体琼脂培养基 250g
图片尺寸800x800
【菌类培养基】胰酪大豆蛋白胨琼脂培养基(tsa) 固体培养基 思润生物
图片尺寸750x750
葡萄糖半固体培养基dextrose semisolid medium hb4108 250g品牌:青岛
图片尺寸502x460
pcfa培养基-产品详情-青岛海博生物
图片尺寸1000x1000
普通变形杆菌和奇异变形杆菌的检验
图片尺寸1000x1181
生物实验现象 配的培养基颜色怎么不对啊? 都是lb 第一个100ml 第二个
图片尺寸500x374
lb 固体培养基(干粉)-赛维尔生物服务|产品_servicebio_武汉赛维尔生
图片尺寸1000x1000
什么是培养基?培养基有什么作用?
图片尺寸640x427
微生物培养基实验室质量控制的重要性-学路网-学习路上 有我相伴
图片尺寸900x900
三糖铁琼脂培养基(tsi)【批发价格,厂家,图片,采购】-中国制造网,青岛
图片尺寸698x1181
固体培养基中的琼脂含量大约为多少 爱问知识人
图片尺寸570x228
当微生物化身艺术品……
图片尺寸1080x540